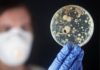
Des bactéries ultra-résistantes tuent 8 000 Japonais par an

Archive
Une impressionnante parade de 1000 samouraïs bientôt à Nikkô
L'incroyable festival du sanctuaire shinto Tôshô-gû à Nikkô a lieu chaque année en mai et en octobre. C'est l'occasion d'assister à des démonstrations d'archerie...